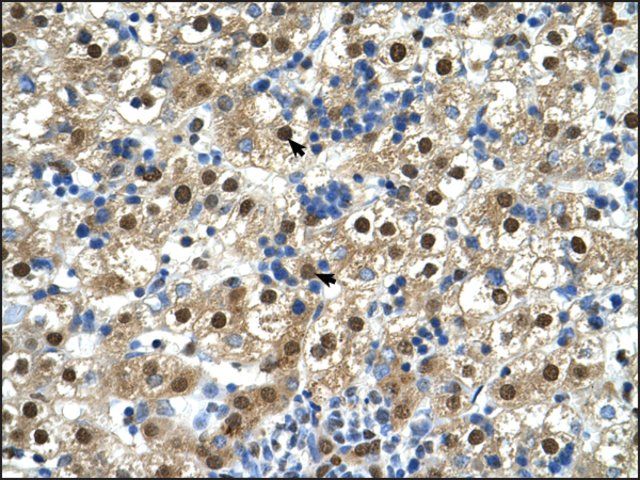

您的位置:首页 > 产品中心 > Anti-GDE1 antibody produced in rabbit
Anti-GDE1 antibody produced in rabbit
产品别名
Anti-GDE1 antibody produced in rabbit
Anti-GDE1
Anti-363E6.2
基本信息
| NACRES | NA.41 |
| General description【一般描述】 | GDE1 codes for the integral membrane protein, glycerophosphodiester phosphodiesterase that is involved in lipid metabolism. It catalyzes anandamide biosynthesis in mouse brain. Rabbit Anti-GDE1 antibody recognizes canine, human, mouse, rat, and bovine GDE1. |
| Immunogen【免疫原】 | Synthetic peptide directed towards the N terminal region of human GDE1 |
| Application【应用】 | Rabbit Anti-GDE1 antibody is suitable for western blot applications at a concentration of 0.5 μg/ml. It can also be used for immunohistochemistry at 4-8 μg/ml. |
| Biochem/physiol Actions【生化/生理作用】 | GDE1 has glycerophosphoinositol phosphodiesterase activity. It has little or no activity towards glycerophosphocholine. GDE1 activity can be modulated by G-protein signaling pathways. |
| Sequence【序列】 | Synthetic peptide located within the following region: LRVFSFEPVPSCRALQVLKPRDRISAIAHRGGSHDAPENTLAAIRQAAKN |
| Physical form【外形】 | Purified antibody supplied in 1x PBS buffer with 0.09% (w/v) sodium azide and 2% sucrose. |
产品性质
| biological source【生物来源】 | rabbit |
| Quality Level【质量水平】 | 100 |
| conjugate【偶联物】 | unconjugated |
| antibody form【抗体形式】 | affinity isolated antibody |
| antibody product type | primary antibodies |
| clone【克隆】 | polyclonal |
| form【形式】 | buffered aqueous solution |
| mol wt【分子量】 | 38 kDa |
| species reactivity | bovine, guinea pig, mouse, rat, dog, rabbit, human |
| concentration【浓度】 | 0.5 mg - 1 mg/mL |
| technique(s) | immunohistochemistry: suitable western blot: suitable |
| NCBI accession no.【NCBI登记号】 | NP_057725 |
| UniProt accession no.【UniProt登记号】 | Q9NZC3 |
| shipped in【运输】 | wet ice |
| storage temp.【储存温度】 | −20℃ |
| Gene Information | human ... GDE1(51573) |
产品说明
| Disclaimer【免责声明】 | Unless otherwise stated in our catalog or other company documentation accompanying the product(s), our products are intended for research use only and are not to be used for any other purpose, which includes but is not limited to, unauthorized commercial uses, in vitro diagnostic uses, ex vivo or in vivo therapeutic uses or any type of consumption or application to humans or animals. |
安全信息
| Storage Class Code【储存分类代码】 | 12 - Non Combustible Liquids |
| WGK | WGK 3 |





